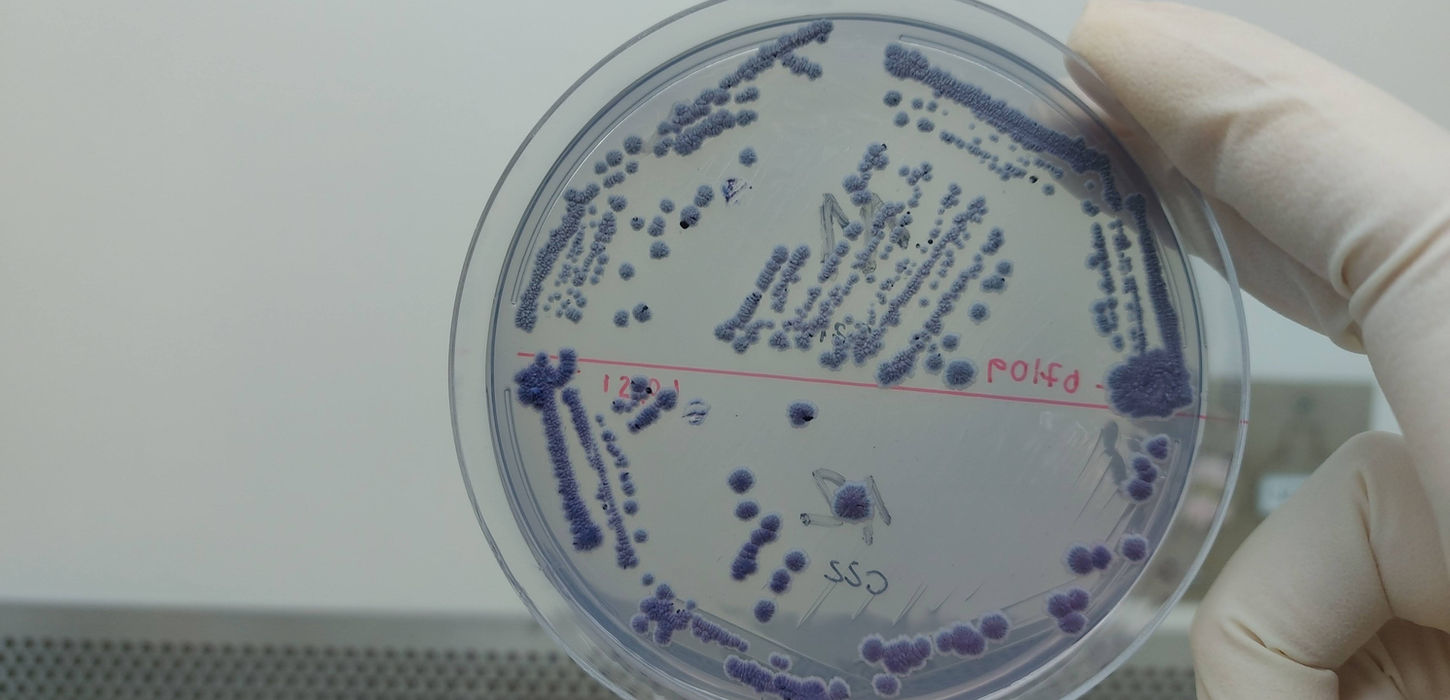

PRODUTO

Multikit Vital-Yan
DISPONIBILIDADE
15 dias para despacho
Descrição
O Multikit Vital-Yan é composto por 100 testes de monitoramento, dividido em análises microbiológicas, físico-químicas e de sistema de análise de resultados e de recomendação. Com o Multikit, o laboratório de microbiologia industrial terá acesso a protocolos e metodologias atualizadas e inovadoras, permitindo elevar o controle de qualidade nas análises de rotina. Com o MultiKit, é possível monitorar o vigor das leveduras na fermentação (através dos testes rápidos de viabilidade e vitalidade celular), detectar as leveduras de partida e a entrada de leveduras contaminantes do processo (através do uso do meio de cultivo exclusivo da Lievito), isolar e armazenar leveduras de interesse (catálogo/banco de leveduras do processo - modelo LIEVITO) e avaliar a qualidade da matéria prima (através da concentração do nitrogênio amino livre no mosto - YAN yeast assimilable nitrogen). O Multikit conta com um sistema de análise de resultados, onde é possível realizar ajustes operacionais na fermentação visando a economia (adição racional e fundamentada de nutrientes) com consequente aumento na qualidade e gestão do processo fermentativo.
Conteúdo
Kit Vital Microbiológico para vitalidade e monitoramento de leveduras
12 placas de Petri contendo o meio de cultivo seletivo (exclusividade LIEVITO)
4 placas de YPD
1 pacote (5 uni.) de alça de esfregaço
1 corante (300 uL)
1 desaglomerador celular (300 uL)
Total de análises: 04 plaqueamentos (triplicata semanal); 04 testes de vitalidade celular
Kit Vital Físico-Químico para vitalidade de leveduras
1 placa de 96 poços
1 reagente colorimétrico (1 mL)
Total de análises: 32 testes (triplicata diária) rápidos de vitalidade celular
Kit Físico-Químico de quantificação de YAN (yeast assimilable nitrogen)
1 frasco de Agente Colorimétrico (40 mL)
Licença de sistema de recomendação e análise de dados válida de acordo com a quantidade de kits (exclusividade LIEVITO)
Total de análises: 68 testes rápidos de detecção de nitrogênio assimilável do mosto e do vinho centrifugado
Todos os componentes esterilizados e prontos para uso. Indica-se a realização do treinamento técnico.
Produto P&D&I Lievito. Esse produto permite o seu laboratório industrial internalizar as análises do processo de fermentação e otimizar os ajustes de insumos (como adição de nutrientes) melhorando produtividade e reduzindo custos. Conta com sistema de recomendação de apoio.

true